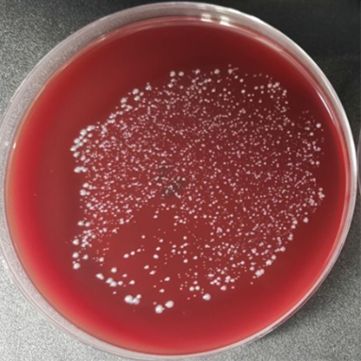
产品封面图

万千商家帮你免费找货
0 人在求购买到急需产品
- 详细信息
- 文献和实验
- 技术资料
- 库存:
100
- 英文名:
Novosphingobium gossypii
- 保质期:
详见说明书
- 供应商:
上海晅科生物科技有限公司
- 保存条件:
2-8℃
- 规格:
冻干粉/菌液
菌种名称:棉花新鞘氨醇菌
拉丁学名:Novosphingobium gossypii
提供形式:冻干粉;斜面;菌液;平板
储存条件:培养物和冻干菌种应在 2~8℃保存,勿长期置于室温。
有效期:6 年

活化步骤: ①准备上述平板 1-2 块;②安瓿管表面消毒后在安全柜中打开, 用酒精灯灼烧顶部,后迅速滴上无菌水使之破裂,随后用镊子 将其敲碎;③吸取 0.5mL 无菌水(置于厌氧环境平衡 24h)打入冻干管,充分溶解菌粉后,打入平板中 200μL/个,涂布均匀; ④将平板置于上述培养条件下培养,7-10 天。

棉花新鞘氨醇菌注意事项:
1、请务必了解培养微生物需要注意的安全事项,默认由微生物专业技术人员操作;
2、建议严格按照 培养说明来操作,认真阅读说明,尤其是要点提示部分,并记录好菌种编号和菌种制作日期(批号);
3、使用前,认真阅读并理解随货的“菌种培养说明”和“开管说明”如有任何疑问,请于操作前咨询我司。
4、如若有菌种复苏不活或污染等情况,请在收到菌种后1个月内联系我司,逾期将不予受理。

菌种保藏是指保持微生物菌株的活力和遗传性状的技术。微生物在使用和传代过程中容易发生污染、变异甚至死亡,因而常常造成菌种的衰退。菌种保藏的目的就是使菌株存活、不丢失、不污染杂菌、不发生或少发生变异,保持菌种原有的活性和各种特征。菌种保藏的基本原理是使微生物的生命活动处于半永久性的休眠状态,也就是将微生物的新陈代谢作用限制在最低范围内。
实验室常用的保菌方法有:甘油保菌法、斜面保菌法、穿刺保菌法、液体石蜡覆盖保藏法、沙土保藏法、冷冻干燥法。微基生物在以上几种菌种保藏方法的基础上,开发出了保菌效果更好瓷珠保菌法。

| 酿酒酵母 VL6-48 | Saccharomyces cerevisiae Meyen ex E.C. Hansen, | 冻干粉;斜面;菌液;平板 | |
| 海源菌 | Idiomarina sp. | 冻干粉;平板 | |
| 枯草芽孢杆菌 | Bacillus subtilis | 冻干粉;斜面;菌液;平板 | |
| 生癌肠杆菌 | Enterobacter cancerogenus | 冻干粉;斜面;菌液;平板 | |
| 类肠膜魏斯菌 | Weissella paramesenteroides | 冻干粉;菌液;平板 | |
| 基氏含铜菌 | Cupriavidus gilardii | 冻干粉;斜面;菌液;平板 | |
| 灰色奈瑟氏球菌 | Neisseria cinerea | 冻干粉;平板 | |
| 宋氏鲸杆菌 | Cetobacterium somerae | 冻干粉;菌液;平板 | |
| 共生梭菌 | Clostridium symbiosum | 冻干粉;平板 | |
| 乳酪短杆菌 | Brevibacterium casei | 冻干粉;斜面;菌液;平板 | |
| 橙色出芽单胞菌 | Gemmatimonas aurantiaca | 冻干粉;平板 | |
| 栖组织普雷沃氏菌 | Prevotella histicola Downes et al. 2008 | 冻干粉;平板 | |
| 大肠埃希氏菌 | Escherichia coli | 冻干粉;斜面;菌液;平板 | |
| 光泽扁平丝菌 | Planifilum fulgidum | 冻干粉;平板 |
风险提示:丁香通仅作为第三方平台,为商家信息发布提供平台空间。用户咨询产品时请注意保护个人信息及财产安全,合理判断,谨慎选购商品,商家和用户对交易行为负责。对于医疗器械类产品,请先查证核实企业经营资质和医疗器械产品注册证情况。
 文献和实验
文献和实验干旱等非生物胁迫因素导致作物在形态、生理、生物化学及细胞水平上产生一些不利于其生长的反应,严重地阻碍着现代农业的发展。随着全球气候变暖和人类活动加剧,干旱有明显加重的趋势。棉花生产是纺织工业及国防建设的重要物质基础,也是中国农业重要组成部分,对中国国民经济的发展有着重要的影响,而且在世界棉花贸易市场上也起着举足轻重的作用。但是,每年由于旱灾引起的棉花年减产量达总量的 30% 以上,干旱已经成为限制棉花生产的首要非生物因素,实践证明采用传统的育种手段很难解决这一问题,因此,克隆抗旱基因并采用基因
三句话读懂一篇 CNS:为什么有人总是容易饿、吃得多;AI 发现 165 个新的癌基因...
技术开发出 EMOGI 新算法,成功识别到 165 个以往未知的癌基因,这类基因并非发生突变后才致癌,其通过表达失调致癌。 该工作为开发生物标记物和靶向癌症治疗及开辟了新的前景,人类离战胜癌症又近了一步!图 3:来源 Nature machine intelligence 4. Cell Stem Cell: 建立患者来源的首个宫颈癌类器官模型 宫颈癌是由人乳头瘤病毒(HPV)感染引起的妇科恶性肿瘤,目前还没有研究人类宫颈组织的良好模型。 2021 年 4 月 13 日,荷兰乌德勒支大学
类似于大蒜素的广谱性种子处理杀菌剂。 性能 纯品无色油状透明液体,。易溶于乙醚、氯仿、乙醇、冰醋酸等有机溶剂。工业品为微黄色油状透明液体,具有大蒜臭味。对温血动物中等毒性。杀菌广谱。1-100mg/l浓度下可抑制棉花疽菌、立枯菌、枯萎菌、黄萎菌、水稻白叶枯菌、稻瘟菌、恶苗菌、甘薯黑斑菌、麦类赤霉菌、条纹菌、腥黑穗菌、苹果炭疽菌、黄瓜蔓割菌等多种真菌和细菌。 应用 此药剂的应用以种子处理为主,防治水稻烂秧病、恶苗病、稻瘟病、棉花苗期病害、苜蓿炭疽病和茎斑病